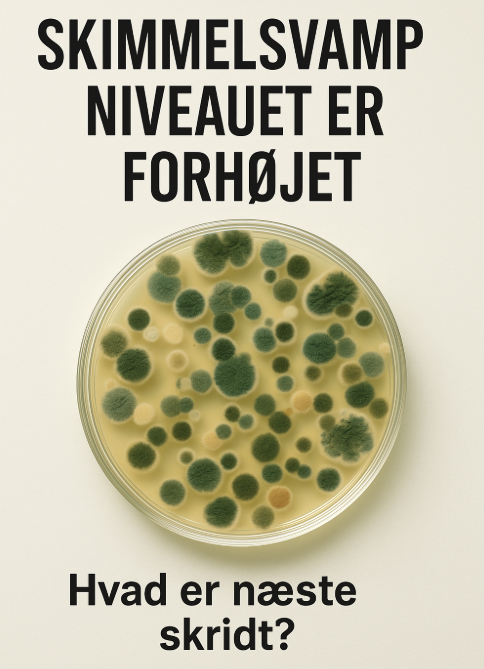

Skimmelsvamp lufttest som indikator
Den lufttest, du allerede har fået foretaget, fungerer som en indikator-test. Den giver et indikator billede af, om der er for mange skimmelsvampesporer i luften, men den fortæller ikke præcist, hvor problemet stammer fra, eller hvilke arter af skimmelsvamp der er tale om. Derfor anbefaler vi altid, at man går videre med en mere valid og detaljeret test, hvis niveauet er for højt.
Hvorfor vælge en skimmelsvamp DNA-støvtest?
Hos TESTdinBOLIG anbefaler vi, at du følger op med en skimmelsvamp DNA-støvtest. Denne test giver en langt mere nøjagtig analyse, fordi den:
Påviser skjulte skimmelkilder (ikke kun det, der svæver i luften i testøjeblikket).
Identificerer de konkrete arter af skimmelsvamp – hvilket kan være afgørende i en sag med fx udlejer eller forsikring.
Dækker et længere tidsrum, da støv opsamler spor over tid og dermed giver et mere repræsentativt billede end en enkelt luftmåling.
Indhold i en komplet skimmelsvamp DNA test rapport:✅ Analyse af støvprøven – testet med avanceret DNA-teknologi
✅ Artsbestemmelse – viser præcis hvilke skimmelsvampe der er til stede
✅ Mængdeangivelse – hvor meget skimmel der er fundet (lavt, moderat eller højt niveau)
✅ Inddeling i fugtrelaterede grupper – afslører om svampene typisk stammer fra fugt, vandskader eller almindeligt støv
✅ Sammenligning med referenceværdier – så du kan se, om resultaterne er normale eller forhøjede
✅ Risikovurdering – tydelig indikation af, om der er tegn på skjult skimmel i boligen
✅ Letforståelig konklusion – samlet opsummering i et sprog, alle kan forstå
✅ Grafiske oversigter og tabeller – giver dig et hurtigt overblik over resultaterne
Spar penge og stå stærkere
Hvis dit problem viser sig at kræve et eksternt skimmelfirma, skal du vide, at de i langt de fleste tilfælde selv vil vælge at lave en DNA-støvtest. Forskellen er blot, at du hos dem både betaler for testen og for deres tid, kørsel og konsulentarbejde.
Ved at have en DNA-støvtest klar fra starten kan du:
Fremvise en professionel og anerkendt rapport allerede ved første møde.
Undgå at betale for en test, du i forvejen har fået lavet – til en langt lavere pris end et skimmelfirma tilbyder.
Spare penge og samtidig få en stærkere position i forhold til både boligforening, udlejer eller forsikringsselskab.
Vores skimmelsvamp anbefaling
Har du fået en rapport, der viser forhøjet niveau i din lufttest → tag det alvorligt.
Suppler med en DNA-støvtest for at få det fulde overblik.
Brug rapporten som dokumentation – både til egen afklaring og hvis der senere skal involveres professionelle.
På den måde undgår du unødvendige udgifter, og du står stærkere, hvis der skal træffes beslutninger om sanering eller juridiske skridt.
Hvad er næste skridt hvis skimmelsvamp DNA støv testen er positiv
Hos TESTdinBOLIG efterlader vi ingen på perronen – vi hjælper dig trygt videre. Vi udfører ikke selv skimmelsvamp-rådgivning eller sanering, men fokuserer udelukkende på at levere uafhængige og præcise tests.
Hvis din DNA-test viser et positivt resultat, kan det være en jungle at google sig frem til det rigtige skimmelfirma. Derfor tager vi gerne en dialog med dig og kan anbefale troværdige og erfarne skimmelsvamp-eksperter, som du kan tage den videre kontakt med. På den måde sparer du tid, undgår usikre valg – og kommer hurtigere i mål.
Ring gerne til os på tlf. +45 29718423, hvis der er nogle spørgsmål.